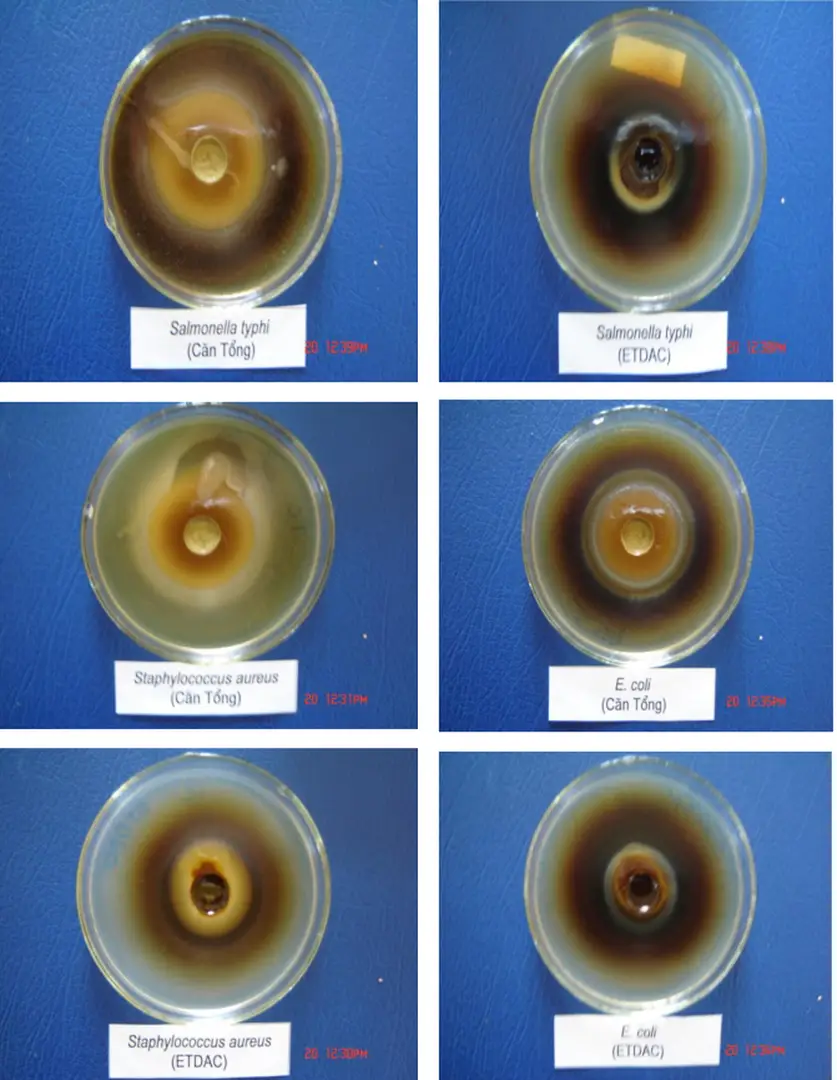
Hình 2.1.  Ảnh được gây ức chế xung quanh giếng thạch

Nhận dạng một số nhóm chất trong cây đỏ ngọn (Cratoxylum prunifolium)
MỤC LỤC
Những nghiên cứu hoá thực vật loài Cratoxylum prunifolium
Từ lá của loài Cratoxylum prunifolium, Xue-Li-Cao, Yoichiro Ito đã dùng phương pháp sắc kí khí lỏng tốc độ cao phân lập được epigallocatechin gallat (XIII.a) và epicatechin gallat (XIII.b) [27]. Theo Nguyễn Liêm và các cộng sự [10], bằng các phản ứng định tính cho biết Cratoxylum prunifolium có chứa các flavonoit, tanin pyrocatechic phitosterol saponin triterpen và các axit hữu cơ, đường khử. Tác giả còn cho biết ở cây đỏ ngọn của Việt Nam không thấy có ancaloit và anthraquinon.
Phạm Đình Hùng, Nguyễn Diệu Liên Hoa và các cộng sự tại Đại học Quốc gia thành phố Hồ Chí Minh đã phân lập được macluraxanthone, 1,7-đihidroxanthone và hai xanthone mới. [6] và cho biết chúng đều có tác dụng diệt muỗi gây sốt rét và có tác dụng tốt trong việc diệt mối. Từ vỏ và rễ cây Cratoxylum prunifolium trồng ở tỉnh Nông Khai miền Nam Thái Lan, Nawong Boonnak và các cộng sự đã chiết bằng điclometan, phân lập các chất bằng sắc kí đã tách được 10 xanthone với sự khác nhau chỉ là ở các mạch nhánh (R1 và R2) [22] và tác giả đã gọi tên chúng là các prunifloron được đánh số từ 1 đến 10.
Cũng từ rễ của thực vật Cratoxylum prunifolium các tác giả Thái Lan lại phát hiện được một anthraquinon mà cấu trúc của nó được tác giả mô tả có dạng XV.
Đối tượng và phương pháp nghiên cứu
Phương pháp khảo sát và xác định cấu trúc hoá học các hợp chất Các chất kết tinh phân lập ra được xác định những tính chất vật lý đặc trưng: màu sắc, mùi vị, hệ số Rf, điểm nóng chảy, ghi các loại phổ như: phổ tử ngoại (UV), phổ hồng ngoại (FT-IR), phổ cộng hưởng từ hạt nhân 1H- NMR, phổ 13C- NMR, tuỳ theo từng loại chất. Các số liệu phổ thực nghiệm của các chất sạch được dùng để nhận dạng cấu trúc hoá học của chúng.
Các dịch chiết từ cây đỏ ngọn (Cratoxylum prunifolium Kurtz) 1. Các dịch chiết
Như vậy từ lá cây đỏ ngọn đã thu nhận được 04 phân đoạn cặn là: cặn trong clorofom (ĐC), cặn trong etylaxetat (ĐE), cặn trong butanol (ĐB) và cặn trong metanol (ĐM). Khối lượng chất tổng số được chiết từng phân đoạn lá cây đỏ ngọn (Cratoxylum prunifolium Kurtz).
ĐC 3
Từ 787,4g lá Cratoxylum prunifolium khô chiết nhiều lần bằng etanol 900 đến khi dịch chiết trong suốt không màu, loại bỏ bớt dung môi rượu bằng máy cất quay ở nhiệt độ 500C đến khi dịch chiết còn lại ở dạng xiro đặc, thêm nước, lắc cặn tổng số này với c lorofom đến khi thu được tất cả các chất có thể tan được trong CHCl3 đều được lấy ra hết, cô cạn dung dịch CHCl3 ở nhiệt độ thấp thu đuợc 52,264g chất (kí hiệu các chất ĐC). Phần cặn không tan trong CHCl3 được lắc nhiều lần với EtOAc cho đến khi dịch chiết EtOAc hoàn toàn không màu và trong suốt, cô cạn dịch EtOAc trong máy cất quay thu được 34,654g chất tổng số (kí hiệu là các chất ĐE). Từ 11g cặn từ dịch clorofom của lá đỏ ngọn kí hiệu (ĐC) được phân chia trên sắc kí cột silicagel với các hệ dung môi n-hexan - clorofom với các tỷ lệ tăng dần clorofom từ 0% đến 100% kiểm tra các phân đoạn trên sắc kí lớp mỏng, các phân đoạn giống nhau đem gộp lại và cất loại dung môi thu được ba chất ĐC-1, ĐC-2, ĐC-3.
Rửa giải với các hệ dung môi n- hexan-clorofom (50:1), sau khi cất loại dung môi, cặn thu được kiểm tra trên SKLM trong hệ dung môi B và phát hiện bằng vanilin 1% trong dung dịch CH3OH- H2SO4, kết tinh lại trong dung môi trên thu được 21mg chất rắn, tinh thể hình kim, màu trắng có nhiệt độ nóng chảy 278-2800C và cho các đặc trưng của một tritecpen. Từ 15g cặn chiết etylaxetat của lá cây đỏ ngọn (ký hiệu ĐE) được tiến hành tách các chất trên sắc kí cột silicagel, rửa giải cột sắc kí bằng hệ dung môi clorofom- metanol có tỷ lệ theo độ tăng dần của dung môi phân cực, metanol 0% -100%, kiểm tra các phân đoạn trên sắc kí lớp mỏng, thuốc thử phát hiện (FeCl3 + K3[Fe(CN)6]) 1% sau đó gộp các phân đoạn giống nhau, đuổi hết dung môi và kết tinh lại thu đựơc chất (ĐE1). Trong quá trình nghiên cứu hóa thực vật cần phải tôn trọng nguyên tắc chung là không được làm thay đổi cấu trúc hóa học của các chất sẵn có trong thực vật và không làm ảnh hưởng đến thành phần hoá học của chúng tại thời điểm lấy mẫu.
Dùng các thuốc thử đặc hiệu để phát hiện các nhóm hợp chất thiên nhiên có hoạt tính sinh lý cao trong thực vật [3] cho thấy trong dịch chiết bằng clorofom của lá cây đỏ ngọn có chứa các axit hữu cơ, streroit, triterpenoit. Bằng phương pháp phân lập trên, từ dịch chiết bằng clorofom của lá cây đỏ ngọn chúng tôi đã thu được 3 hợp chất sạch là: một tritecpen và hai steroit; còn dịch chiết etylaxetat phân lập được axit gallic và hỗn hợp các xanthone với flavonoit.

Phổ 13 C-NMR của Stigmasterol [16]
Dựa trên phân tích các số liệu về phổ EI-MS, FT-IR và các phổ NMR của hợp chất ĐC-3 hoàn toàn phù hợp với cấu trúc của chất β-sitosterol.
Phổ 13 C-NMR của β-sitosterol [16]
Các chất thu được từ dịch chiết etylaxetat (ĐE) được phân chia trên sắc kí cột với chất hấp phụ silicagel, rửa giải bằng hỗn hợp dung môi clorofom- metanol với tỉ lệ metanol tăng dần từ 0% - 100% thu được nhiều phân đoạn khác nhau trong đó có phân đoạn CHCl3:MeOH (9:1) chứa một chất sạch được kí hiệu là chất ĐE-1. Những số liệu về phổ NMR của chất ĐE-1 hoàn toàn phù hợp với phần mềm ACD/NMR của axit gallic (xem bảng 3.4). Số liệu phổ NMR của ĐE-1 và số liệu phổ NMR trong phần mềm ACD/NMR của axit gallic.
Trên cơ sở phân tích các số liệu về phổ FT-IR, NMR và phần mềm ACD/NMR. Từ dịch chiết etylaxetat, ngoài axit gallic còn thu được một số phân đoạn không sạch khác có chứa các chất cho phản ứng màu với xianidin; cho phản ứng tạo màu xanh đen với FeCl3. Các mẫu này có chứa hỗn hợp các flavonoit, các polyphenol có hệ số Rf rất gần nhau và việc tách chúng bằng cột silicagen chưa đạt được sự phân chia tốt.
Khi rửa giải bằng CH3OH 100% thu được phân đoạn cho các phản ứng màu giống dịch chiết tổng số bằng n-butanol. Khi thực hiện phản ứng thuỷ phân các mẫu này trong axit HCl 2N thu được glucozơ và axit gallic. Từ kết quả thuỷ phân này có thể cho rằng các phân đoạn chiết bằng etylaxetat và bằng n-butanol đều chứa các tannin và đó là galotanin.
Tuy nhiên các tannin ấy được tạo ra bởi liên kết C-glycoside hay O-glycoside cấu trúc và thứ tự liờn kết của chỳng như thế nào, cũn chưa được làm rừ vỡ chưa tỏch chỳng thành các đoạn sạch. Các chất tổng số được chiết, tách bằng dung môi có độ phân cực khác nhau sau khi làm khô kiệt, loại bỏ hoàn toàn dung môi được gửi tới phòng thí nghiệm vi sinh trường Đại học Y khoa Thái Nguyên để thử tác dụng sinh học của chúng. Kết quả được nêu ở bảng 2.3 và hình 2.1 cho thấy tất cả các chất thu được từ các dịch chiết của lá cây đỏ ngọn đều có tác dụng kháng khuẩn đối với khuẩn Staphylococcus, E.coli, Salmonella typhi.
Chúng tôi cũng đã gửi mẫu chiết bằng etylaxetat và chiết bằng etanol sau khi đã làm sạch dung môi đến cơ sở sản xuất kinh doanh thuốc thành phẩm, thực phẩm chức năng Y học cổ truyền Thái Nguyên. Các mẫu đều có tác dụng tốt đối với việc chăm sóc sức khoẻ con người, các chất có trong các dịch chiết trên đều không gây độc đối với con người.